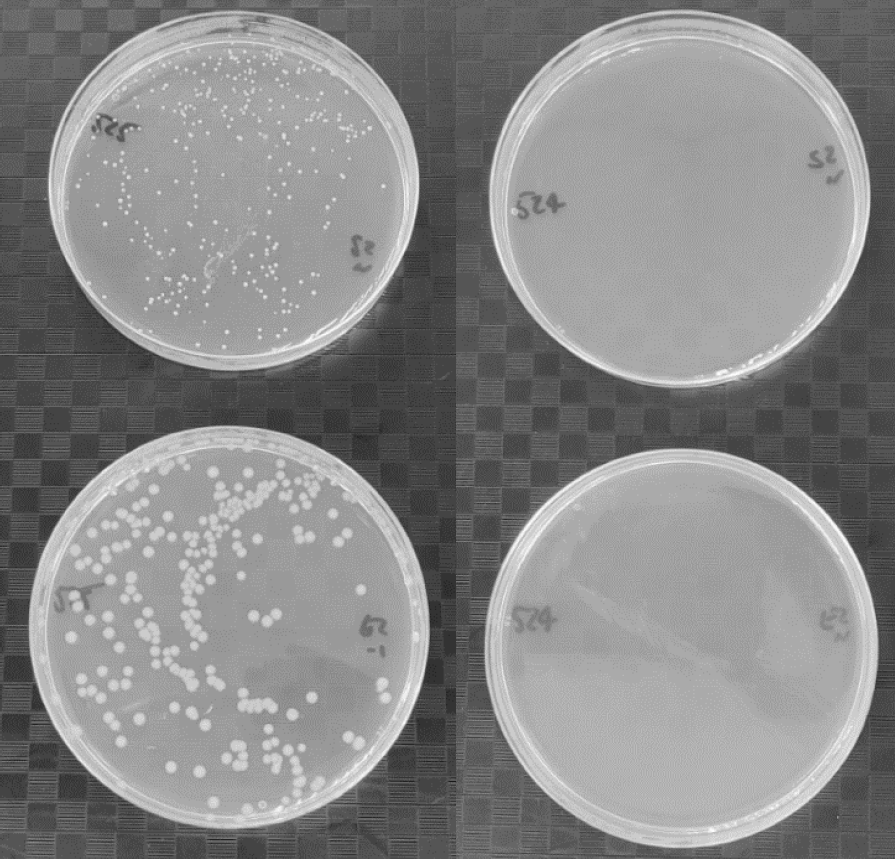

VENA® Aseptisil, la solution développée par nos soins pour lutter contre les bactéries - Etude de cas
Contexte
Compte tenu de l'importance de la propreté des lignes de production d'aliments et de boissons et des usines de transformation, et de la susceptibilité de ces secteurs à subir des contaminations au cours de leurs processus de production, avec de graves conséquences pour la chaîne de production ou la santé publique, Venair propose dans son catalogue nutritionnel un silicone auto-développé aux propriétés antimicrobiennes qui garantit une réduction jusqu'à 99,9 % des principales bactéries de l'industrie agro-alimentaire.
Test ISO 22196:2011 et croissance bactérienne dans le silicone standard (à gauche) et Vena®Aseptisil (à droite). Contre MRSA (en haut) et E. Coli (en bas).
Vena® Aseptisil est présenté comme une option permettant de personnaliser et d'apporter un plus en matière de protection et de sécurité à nos produits en silicone dans les cas où les bactéries peuvent constituer un problème sérieux.
Vena® Aseptisil agit en inhibant la croissance des bactéries le long des parois du tuyau, évitant non seulement la dégradation du silicone mais aussi tout changement de couleur, d'odeur et de saveur des produits à l'intérieur des tuyaux.
L'application réelle de VENA® Aseptisil
Vena® Aseptisil a été mis en œuvre avec succès chez une entreprise alimentaire croate de premier plan qui fournit des marmelades et différentes crèmes aux industries de la boulangerie.

Ils cherchaient une alternative au tuyau qu'ils utilisaient pour leurs lignes de remplissage de fruits. Nous avons proposé une construction similaire comprenant Vena®Aseptisil comme couche interne pour assurer la protection contre les bactéries pendant le processus de remplissage.
Défis rencontrés et solutions


Conclusions
Avec la mise en œuvre de Vena® Aseptisil chez ce client croate, et compte tenu de son entière satisfaction à l'égard de la solution, l'efficacité de ce produit est évidente lorsqu'il s'agit de fournir une garantie supplémentaire de protection et de sécurité dans les processus. L'efficacité de ce produit est évidente lorsqu'il s'agit de fournir une garantie supplémentaire de protection et de sécurité dans les processus, en particulier ceux où la contamination bactérienne peut constituer un problème important et un risque sérieux.
Avec cette mise à niveau de Vena® Sil 650V, nous n'avons pas seulement obtenu la protection souhaitée contre les contaminants, mais aussi une grande amélioration technique en augmentant la flexibilité du tuyau pour une meilleure adaptabilité à l'installation du client.
Ce type de projet démontre la capacité de Venair à personnaliser et à adapter les solutions aux problèmes de transfert. En offrant toujours les meilleures solutions pour les applications de nos clients.